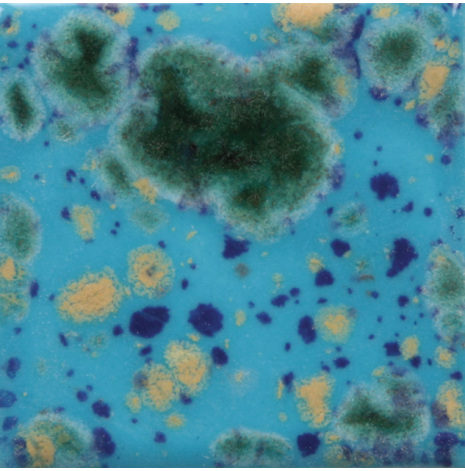

Landväljare
Svenska
SEK
Sök
Specifikationer
Varumärke
Mayco är en tillverkare från USA av glasyrer för stengods och lergods och diverse tillbehör för keramik. De tillverkar även skröjbrända gjutna keramiska föremål så kallade bisque, färdiga att dekorera med glasyr och bränna.
Inspiration på glasyrkombinationer.
Dokument
Dokument (1)
Andra varor från samma fabrikat
Ej i lager
Artnr. EG005
260 SEK
I lager
Artnr. EG004
260 SEK
I lager
Artnr. EG003
260 SEK
I lager
Artnr. EG002
260 SEK
Andra varor från samma varugrupp
I lager
Artnr. CG-962
319 SEK
I lager
Artnr. S-2724
319 SEK
Ej i lager
Artnr. CG-713
319 SEK
I lager
Artnr. CG-964
319 SEK